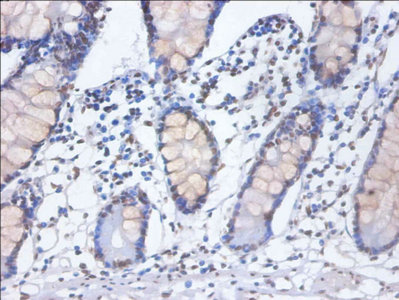

HNRNPD Antibody
-
中文名稱:HNRNPD兔多克隆抗體
-
貨號:CSB-PA02544A0Rb
-
規格:¥440
-
圖片:
-
Western blot
All lanes: HNRNPD antibody at 2µg/ml
Lane 1: 293T whole cell lysate
Lane 2: Hela whole cell lysate
Lane 3: Jurkat whole cell lysate
Secondary
Goat polyclonal to rabbit IgG at 1/10000 dilution
Predicted band size: 39, 37, 33, 31 kDa
Observed band size: 39 kDa -
Immunohistochemistry of paraffin-embedded human small intestine tissue using CSB-PA02544A0Rb at dilution of 1:100
-
Immunohistochemistry of paraffin-embedded human prostate tissue using CSB-PA02544A0Rb at dilution of 1:100
-
-
其他:
產品詳情
-
產品名稱:Rabbit anti-Homo sapiens (Human) HNRNPD Polyclonal antibody
-
Uniprot No.:
-
基因名:HNRNPD
-
別名:ARE binding protein AUFI type A antibody; AU-rich element RNA-binding protein 1 antibody; AUF antibody; AUF1 antibody; AUF1A antibody; Heterogeneous nuclear ribonucleoprotein D0 antibody; hnRNP D antibody; hnRNP D0 antibody; Hnrnpd antibody; hnRNPD0 antibody; HNRPD antibody; HNRPD_HUMAN antibody; P37 antibody
-
宿主:Rabbit
-
反應種屬:Human
-
免疫原:Recombinant Human Heterogeneous nuclear ribonucleoprotein D0 protein (18-355AA)
-
免疫原種屬:Homo sapiens (Human)
-
標記方式:Non-conjugated
本頁面中的產品,HNRNPD Antibody (CSB-PA02544A0Rb),的標記方式是Non-conjugated。對于HNRNPD Antibody,我們還提供其他標記。見下表:
-
克隆類型:Polyclonal
-
抗體亞型:IgG
-
純化方式:>95%, Protein G purified
-
濃度:It differs from different batches. Please contact us to confirm it.
-
保存緩沖液:Preservative: 0.03% Proclin 300
Constituents: 50% Glycerol, 0.01M PBS, PH 7.4 -
產品提供形式:Liquid
-
應用范圍:ELISA, WB, IHC
-
推薦稀釋比:
Application Recommended Dilution WB 1:1000-1:5000 IHC 1:20-1:200 -
Protocols:
-
儲存條件:Upon receipt, store at -20°C or -80°C. Avoid repeated freeze.
-
貨期:Basically, we can dispatch the products out in 1-3 working days after receiving your orders. Delivery time maybe differs from different purchasing way or location, please kindly consult your local distributors for specific delivery time.
-
用途:For Research Use Only. Not for use in diagnostic or therapeutic procedures.
相關產品
靶點詳情
-
功能:Binds with high affinity to RNA molecules that contain AU-rich elements (AREs) found within the 3'-UTR of many proto-oncogenes and cytokine mRNAs. Also binds to double- and single-stranded DNA sequences in a specific manner and functions a transcription factor. Each of the RNA-binding domains specifically can bind solely to a single-stranded non-monotonous 5'-UUAG-3' sequence and also weaker to the single-stranded 5'-TTAGGG-3' telomeric DNA repeat. Binds RNA oligonucleotides with 5'-UUAGGG-3' repeats more tightly than the telomeric single-stranded DNA 5'-TTAGGG-3' repeats. Binding of RRM1 to DNA inhibits the formation of DNA quadruplex structure which may play a role in telomere elongation. May be involved in translationally coupled mRNA turnover. Implicated with other RNA-binding proteins in the cytoplasmic deadenylation/translational and decay interplay of the FOS mRNA mediated by the major coding-region determinant of instability (mCRD) domain. May play a role in the regulation of the rhythmic expression of circadian clock core genes. Directly binds to the 3'UTR of CRY1 mRNA and induces CRY1 rhythmic translation. May also be involved in the regulation of PER2 translation.
-
基因功能參考文獻:
- Our study provides new insights into the regulation of APP pre-mRNA processing, supports the role for nELAVLs as neuron-specific splicing regulators and reveals a novel function of AUF1 in alternative splicing. PMID: 28291226
- Both hnRNP D and DL are able to control their own expression by alternative splicing of cassette exons in their 3'UTRs. Exon inclusion produces mRNAs degraded by nonsense-mediated decay. Moreover, hnRNP D and DL control the expression of one another by the same mechanism. PMID: 29263134
- Lnc_ASNR interacted with the protein ARE/poly (U)-binding/degradation factor 1(AUF1), which is reported to promote rapid degradation of the Bcl-2 mRNA, an inhibitor of apoptosis. Lnc_ASNR binds to AUFI in nucleus, decreasing the cytoplasmic proportion of AUF1 which targets the B-cell lymphoma-2 (Bcl-2) mRNA. PMID: 27578251
- in the present case, the identified mutations in HNRNPD and risk polymorphisms are plausible molecular players in the manifestation of CD. PMID: 28300425
- AUF1 p45 triggers the RNA switch in the flaviviral genome that is crucial for viral replication. These findings represent an important example of how cellular (host) factors promote the propagation of RNA viruses PMID: 29263261
- AUF1 might be a potential player in renal tubulointerstitial fibrosis through modulation of TGF-beta signal transduction via posttranscriptional regulation of Nedd4L. PMID: 28986222
- Results indicate that the IL-6/STAT3/NF-kappaB positive feedback loop includes AUF1 and is responsible for the sustained active status of cancer-associated fibroblasts. PMID: 27248826
- Depletion of AUF1 abolishes the global interaction of miRNAs and AGO2. AUF1 functions in promoting miRNA-mediated mRNA decay globally. PMID: 28334781
- High AUF1 expression is associated with esophageal squamous cell carcinoma. PMID: 27826622
- Arginine methylation improves the viral RNA chaperone activity of AUF1 p45. PMID: 27520967
- These results suggest that the post-transcriptional regulation of ATX expression by HuR and AUF1 modulates cancer cell migration. PMID: 27784781
- analysis of the effect of the N-terminal RNA recognition motif on AUF1 PMID: 27437398
- We found a C-rich element (CRE) in mu-opioid receptor (MOR) 3'-untranslated region (UTR) to which poly (rC) binding protein 1 (PCBP1) binds, resulting in MOR mRNA stabilization. AUF1 phosphorylation also led to an increased interaction with PCBP1. PMID: 27836661
- Findings indicate that hnRNP D and arginine methylation play important roles in the regulation of Flt-1 mRNA alternative polyadenylation. PMID: 26728997
- Down-regulation of hnRNPD inhibits the proliferation of esophageal squamous cell carcinoma cells by promoting cell apoptosis. PMID: 26648300
- in human ovarian, esophageal, and pancreatic cancer tissues, the expression of SOD1 was significantly correlated with that of AUF-1, further supporting the importance of AUF-1 in regulating SOD1 gene expression PMID: 25908445
- hnRNPD has roles in cellular proliferation and survival, besides RNA splicing and stability in oral cancer PMID: 26318153
- These data specify a post-transcriptional mechanism through which AUF1 and YB1 contribute to the normal development of erythropoietic cells, and to non-hematopoietic tissues in which AUF1- and YB1-based regulatory mRNPs assemble on heterologous mRNAs PMID: 25720531
- preserves genomic integrity through its actions on target RNAs PMID: 25366541
- Auf1 may play a role in the elimination of oxidized RNA, which is required for the maintenance of proper gene expression under conditions of oxidative stress PMID: 25486179
- Taken together, these findings proved the inhibitory effect of TP-1 on the growth and metastasis of SMMC-7721 cells, and TP-1 might be offered for future application as a powerful chemopreventive agent against hepatocellular carcinoma (HCC) metastasis. PMID: 25787750
- AUF1 interacts with the EV71 IRES to negatively regulate viral translation and replication. PMID: 25077793
- a novel mechanism by which AUF1 binding and transfer of microRNA let-7 to AGO2 facilitates let-7-elicited gene silencing. PMID: 26253535
- Functional analysis of selected regulated proteins revealed that knockdown of HNRPD, PHB2 and UB2V2 can increase HCMV replication, while knockdown of A4 and KSRP resulted in decreased HCMV replication. PMID: 25910425
- AUF1 has been implicated in controlling a variety of physiological functions through its ability to regulate the expression of numerous mRNAs containing 3'-UTR AREs, thereby coordinating functionally related pathways. PMID: 24687816
- MicroRNA-141 and microRNA-146b-5p have a role in inhibiting the prometastatic mesenchymal characteristics through the RNA-binding protein AUF1 targeting the transcription factor ZEB1 and the protein kinase AKT PMID: 25261470
- IL-6 has a major role in activating breast stromal fibroblasts through STAT3-dependent AUF1 induction PMID: 25231991
- AUF1 p45 promotes West Nile virus replication by an RNA chaperone activity that supports cyclization of the viral genome. PMID: 25078689
- The prolyl isomerase pin1 regulates mRNA levels of genes with short half-lives by targeting specific RNA binding proteins, such as HuR and AUF1. PMID: 24416409
- Our findings suggest that the AUF1 gene may play an important role in hepatocellular carcinoma progression PMID: 24213928
- hnRNP D is critically involved in LDLR mRNA degradation in liver tissue in vivo. PMID: 24158514
- analysis of how AUF1 target mRNAs and how AUF1 binding possibly regulates protein and/or microRNA binding events at adjacent sites PMID: 23940053
- Results suggest that cleavage of AUF1 may be a strategy employed by coxsackievirus B3 (CVB3) to enhance the stability of its viral genome. PMID: 23572232
- Hsp27 and F-box protein beta-TrCP promote degradation of mRNA decay factor AUF1. PMID: 23530064
- ING4 may regulate c-MYC translation by its association with AUF1. PMID: 23603392
- Here authors describe experiments suggesting that AUF1, a host RNA binding protein involved in mRNA decay, plays a role in the infectious cycle of picornaviruses such as poliovirus and human rhinovirus. PMID: 23131833
- EBER1 may disturb the normal homeostasis between AUF1 and ARE-containing mRNAs or compete with other AUF1-interacting targets in cells latently infected by Epstein-Barr virus. PMID: 23012480
- Findings point to a contribution of AUF1 to the deleterious effects of cytokines on beta cell functions and suggest a role for this RNA-binding protein in the early phases of type 1 diabetes. PMID: 22159912
- The binding sites for HuR and AUF1 present in androgen receptor mRNA, defined by their exact target sequences, are the same sequence for both proteins. PMID: 22368252
- AUF1 and HuR bind to VEGFA ARE RNA under both normoxic and hypoxic conditions, and a pVHL-RNP complex determines VEGFA mRNA decay. PMID: 22086907
- the ability of AUF1 isoforms to regulate the mRNA binding and decay-promoting activities of TTP PMID: 22203679
- Data suggest that AUF-1 and YB-1 are required for normal accumulation of beta-globin mRNA in erythroid cells; YB-1 and AUF-1 exhibit sequence-specific binding to 3-prime-untranslated region of beta-globin mRNA. PMID: 22134169
- This review briefly describes the roles of mRNA decay in gene expression in general and ARE-mediated decay (AMD) in particular, with a focus on AUF1 and the different modes of regulation that govern AUF1 involvement in AMD. PMID: 21956942
- Knockdown AUF1 mRNA expression by AUF1 siRNA in MKP-1 WT bone marrow macrophages significantly delayed degradation of IL-6, IL-10 and TNF- alpha mRNAs compared with controls PMID: 21733716
- p16( INK4a) is also a modulator of transcription and apoptosis through controlling the expression of two major transcription regulators, AUF1 and E2F1 PMID: 21799732
- These results suggest that the p38 MAP kinase (MAPK)-MK2-Hsp27 signaling axis may target AUF1 destruction by proteasomes, thereby promoting AU-rich element mRNA stabilization. PMID: 21245386
- p40(AUF1) regulates a critical node within the NF-kappaB signaling pathway to permit IL10 induction for the anti-inflammatory arm of an innate immune response. PMID: 21135123
- Alternatively expressed domains of AU-rich element RNA-binding protein 1 (AUF1) regulate RNA-binding affinity, RNA-induced protein oligomerization, and the local conformation of bound RNA ligands PMID: 20926381
- Leukotriene B(4) BLT receptor signaling regulates the level and stability of cyclooxygenase-2 (COX-2) mRNA through restricted activation of Ras/Raf/ERK/p42 AUF1 pathway PMID: 20489206
- the degradation of bcl-2 mRNA induced by AS1411 results from both interference with nucleolin protection of bcl-2 mRNA and recruitment of the exosome by AUF1. PMID: 20571027
顯示更多
收起更多
-
亞細胞定位:Nucleus. Cytoplasm. Note=Localized in cytoplasmic mRNP granules containing untranslated mRNAs. Component of ribonucleosomes. Cytoplasmic localization oscillates diurnally.
-
數據庫鏈接:
Most popular with customers
-
-
YWHAB Recombinant Monoclonal Antibody
Applications: ELISA, WB, IHC, IF, FC
Species Reactivity: Human, Mouse, Rat
-
Phospho-YAP1 (S127) Recombinant Monoclonal Antibody
Applications: ELISA, WB, IHC
Species Reactivity: Human
-
-
-
-
-